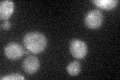
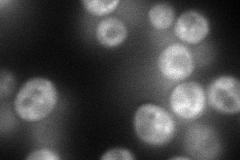
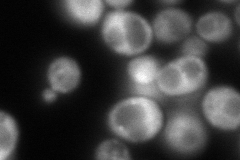
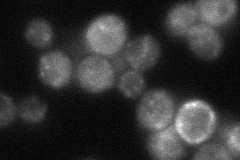

View description
Protein of unknown function; heterooligomeric or homooligomeric complex; peripherally associated with membranes; homologous to human COH1; involved in sporulation, vacuolar protein sorting and protein-Golgi retention
Localization:
Intensity:
Fold change:
Significance:
-
C’ GFP library in SD
cytosol32.31 -
N' NOP1pr-GFP in SD
cytosol,punctate102.682 -
N' TEF2pr-mCherry in SD
cytosol,punctate87.4724 -
N' NATIVEpr-GFP in SD
punctate46.3078 -
N' TEF2pr-VC and Cyto-VN in SD

cytosol29.51 -
C’ GFP library in SD+DTT

cytosol30.860.95No -
C’ GFP library in SD+H2O2

cytosol29.360.9No -
C’ GFP library in Starvation Media

cytosol32.791.01No -
C’ GFP library on the background of Pup2-DaMP

cytosol -
C’ GFP library on the background of CCT mutant

cytosol29.81680.922677No
